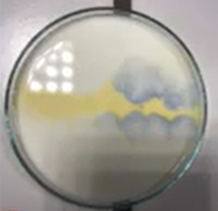

door Filip | 31 aug 2022 | Geen categorie
Magische vloeistof Video 1.Onderzoeksvraag Hoe kun je van een gele oplossing een hele regenboog maken? 2.Voorbereiding Materialen 5 wegwerpbekers; thymolblauw oplossing; natriumwaterstofsulfaatoplossing; citroenzuur oplossing; natriumcarbonaatoplossing;...

door Filip | 31 aug 2022 | Geen categorie
Poets een cent in 60 seconden Video 1.Onderzoeksvraag Hoe kan je een koperen muntje poetsen? 2.Voorbereiding Materialen plaat; schaal; glas; eetlepel; azijn; tafelzout; oude koperen munt. 3. Werkwijze Los twee eetlepels keukenzout op in een glas azijn. Giet de...

door Filip | 30 aug 2022 | Geen categorie
Warm koud Video 1.Onderzoeksvraag Hoe kun je dichtheid aantonen? 2.Voorbereiding Materialen 2 shot glaasjes; getint heet water; getint koud water; vellen papier/plastiek. 3. Werkwijze Vul een borrelglas met getint heet water en een tweede met getint koud water. Bedek...

door Filip | 30 aug 2022 | Geen categorie
Ijzige patronen Video 1.Onderzoeksvraag Hoe maak je ijzige patronen? 2.Voorbereiding Materialen petrischaal; borstel; glas; 25 ml kokend water; 50 gram ureum. 3. Werkwijze Breng 25 ml kokend water en 50 g ureum in een glas. Breng het resulterende mengsel met een...

door Filip | 30 aug 2022 | Geen categorie
Blueberries indicator Video 1.Onderzoeksvraag Hoe kun je een pH-indicator van bosbessen maken? 2.Voorbereiding Materialen blauwe bessen (200 g); heet water (150 ml); 9% tafelazijn (100 ml); citroensap (100 ml); koolzuurhoudend water (koolzuuroplossing, 100 ml); water...

door Filip | 30 aug 2022 | Geen categorie
Blauw-geel-rode indicator Video 1.Onderzoeksvraag Hoe maak je een blauw-geel-rood patroon? 2.Voorbereiding Materialen · maatcilinder van 100 ml · zwavelzuur 0,1 mol/l · natriumcarbonaat · thymolblauwoplossing 3. Werkwijze Giet 80 ml...

door Filip | 30 aug 2022 | Geen categorie
Adem als reagens Video 1.Onderzoeksvraag Hoe kun je een kleur van een oplossing veranderen door er gewoon in te ademen? 2.Voorbereiding Materialen calciumoxide (1 g); gedestilleerd water (300 ml); kolf; 1% fenolftaleïne-oplossing; rietje; beker. 3. Werkwijze We lossen...

door Filip | 30 aug 2022 | Geen categorie
Kleuren met melk Video 1.Onderzoeksvraag Hoe kunnen we kleurenpatronen in melk maken? 2.Voorbereiding Materialen Petrischaal Volle melk Indicatoren: methylrood, broomthymolblauw, thymolblauw oplossingen Natriumhydroxide oplossing 0,1 mol/l Zoutzuuroplossing 0,1 mol/l...

door Filip | 30 aug 2022 | Geen categorie
Waterstofschuim maken en aansteken Video 1.Onderzoeksvraag Hoe kun je een schuim in brand te steken? 2.Voorbereiding Materialen vloeibare zeep; water; glas; zinkkorrels; zoutzuur oplossing; fles; kurk met een gasslang. 3. Werkwijze Meng vloeibare zeep en water in een...

door Filip | 30 aug 2022 | Geen categorie
Hoe magnesium verbrandt in de waterdamp? Video 1.Onderzoeksvraag Hoe verbrandt magnesium in de waterdamp? 2.Voorbereiding Materialen magnesiumstrip; heet water; fenolftaleïne-oplossing; beker; spiritusbrander; pincet; aansteker of lucifers. 3. Werkwijze Verbrand...